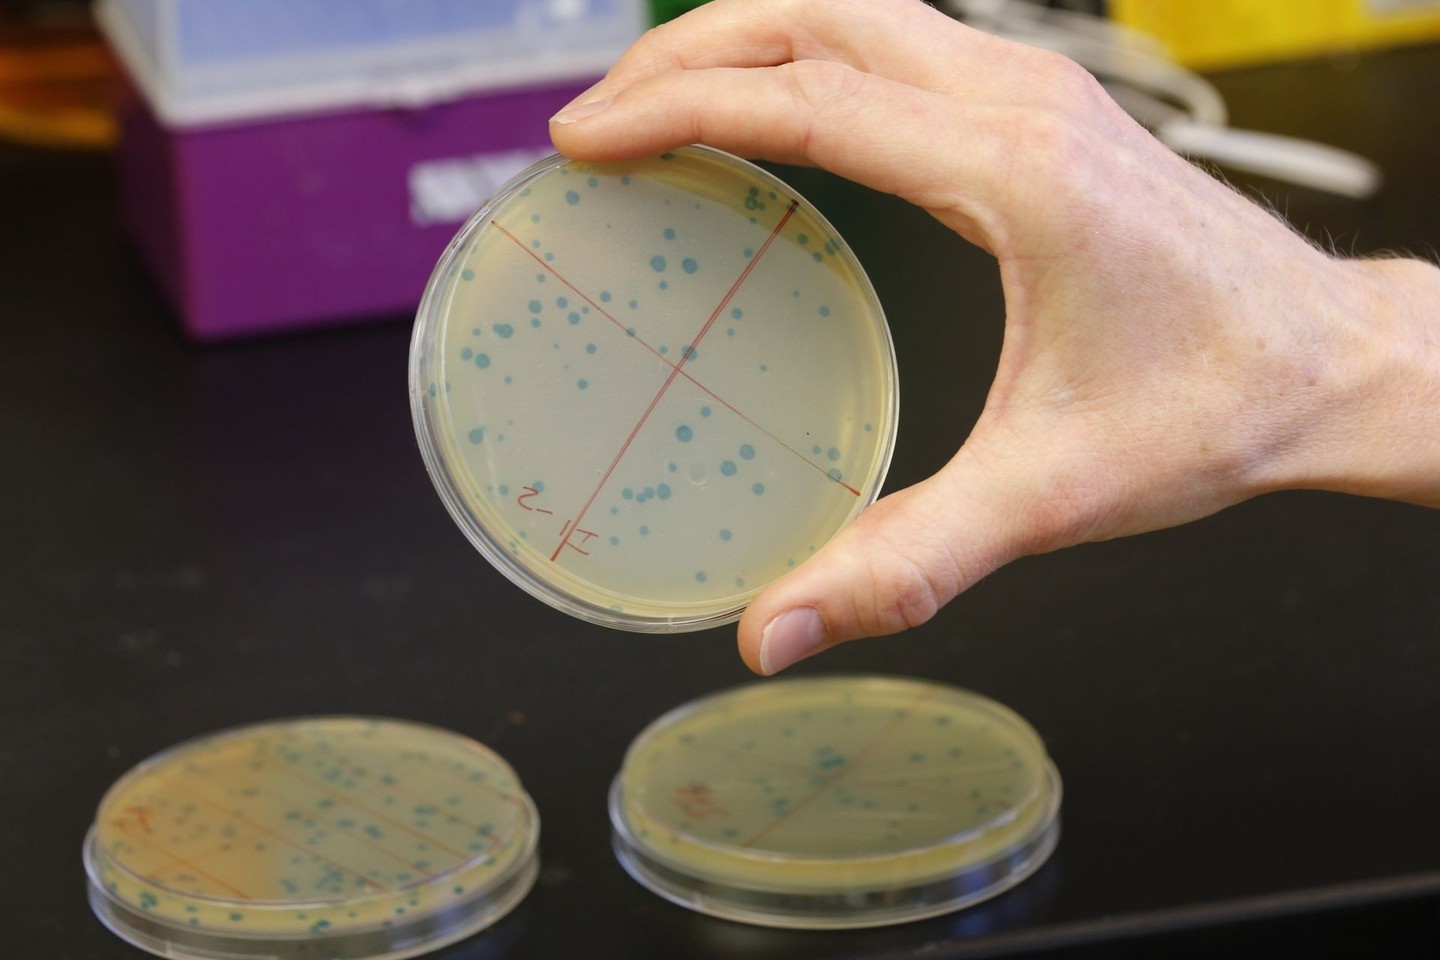

„Kai geriami vaistai, ne veltui sakoma – nuo vieno padeda, devyniems pakenkia. Juk veikliosios medžiagos tabletėje yra labai mažai, gausu pagalbinių medžiagų. Gydymas bakterijomis būtų daug efektyvesnis. Ateityje galbūt tai prasibraus pro žmonių naujovių baimės barjerą. Bus galima pradėti normaliai naudoti visus genetiškai modifikuotus organizmus (GMO). Bakterijos bus visraktis, bet reikia labai daug darbo ir galimybių, norint nukonkuruoti farmacijos įmones“, – LRT radijo laidoje „Ryto garsai“ sakė I.Olendraitė.
Jai antrina ir kolegė Ieva Rauluševičiūtė, kurios teigimu, genetiškai modifikuotos bakterijos jau dabar naudojamos vaistų gamyboje.
Lietuviams teks palaukti
Visame pasaulyje žmonės susiduria su sunkios senatvės padariniais. Vyresnio amžiaus žmones kankina begalės ligų ir įvairios negalios. Senėjimo problema labai aktuali Lietuvai – paskaičiuota, kad iki 2030 metų kas trečias Lietuvos gyventojas bus vyresnis nei 65 metų. Šie metai Lietuvoje paskelbti sveiko senėjimo metais, todėl, pasitelkiant mokslo bei technologijų plėtrą, bandoma prailginti senatvės trukmę ir pagerinti jos kokybę.
Prie šio tikslo prisideda ir Vilniaus universiteto (VU) studentų komanda, kuri sukūrė genetiškai modifikuotų bakterijų senėjimo mechanizmą. Komanda tiki, kad ateityje šią sistemą bus galima pritaikyti ir žmonių ligoms gydyti.
„Kai moksleivių klausėme, kaip galėtume pritaikyti šį projektą, jie sakė – ligoms gydyti. Pavyzdžiui, bakterijas galima patalpinti į žarnyną, jos identifikuotų sutrikimą, bet nereikėtų, kad jos pačios ten užsiliktų, gyventų ir nukonkuruotų natūralią mikroflorą. Naudojant mūsų sistemą, bakterijos patektų į žarnyną, atliktų savo funkciją, identifikuotų sutrikimą, išskirtų jį spalva, kurią galima nuskenuoti, o po kurio laiko žūtų“, – apie projektą pasakoja I.Olendraitė.
Ji sutinka, kad Lietuvoje žmonės itin bijo GMO. Mokslininkė svarsto, kad, jeigu žmonės nenori tokių organizmų savo aplinkoje, nesutiktų būti jais gydomi, todėl, siekiant pritaikyti šį projektą, dar reikia palaukti, kol tam subręs pati visuomenė.
Bakterijos – itin neprognozuojami organizmai. Jos – lyg vandens lašeliai, kurie savo kelionėje gali susilieti su kitais arba net kelis kartus pasidalinti ir visiškai savarankiškai keliauti toliau. I.Rauluševičiūtė atkreipia dėmesį, kad modifikuotų bakterijų produktai jau dabar naudojami, gydant pacientus, sergančius cukriniu diabetu. Tai – viena iš dažniausių senyvo amžiaus žmonių ligų Lietuvoje, tačiau dauguma net nežino, kad jai gydyti pasitelkiama genetinė modifikacija.
„Dažnai genetinę modifikaciją siejame su neigiamais dalykais. Mažai kas žino, iš kur gaunamas dabar naudojamas insulinas. Žmogus gali būti prieš genetiškai modifikuotus organizmus, bet sirgti diabetu ir leistis insuliną, turbūt net nesusimąstydamas, kad tas pats insulinas – genetiškai modifikuotos bakterijos produktas. Jis identiškas žmogaus organizmo gaminam insulinui, bet tai – genetiškai modifikuotas produktas“, – teigia I.Rauluševičiūtė.
Gydant nereikėtų naudoti cheminių medžiagų
Abi LRT radijo pašnekovės mano, kad jų komandos projektas galėtų būti variklis, duosiantis pradžią modifikuotų bakterijų panaudojimui visoms žmonių reikmėms.
„Mano nuomone, genetiškai modifikuotos bakterijos, atliekančios visas mums reikalingas funkcijas, – raktas į ateitį. Pavyzdžiui, modifikuota bakterija geba gaminti nuskausminamuosius vaistus. Tai būtų pigiau, nei gaminti vaistus chemiškai. Be to, būtų mažiau skausminga daryti injekcijas į nugaros smegenis ar kitur. Tokia bakterija gyventų žmogaus organizme ir išskirtų reikiamą vaistų dozę“, – tvirtina I.Rauluševičiūtė.
Anot jos, bakterija būtų užprogramuota taip, kad veiktų kaip pompa: išskirtų vaistus ir žūtų, o po to vėl pakartotų šiuos veiksmus. Mokslininkės tikinimu, norint tokias bakterijas patalpinti į žmogaus organizmą, užtektų vienos injekcijos arba tiesiog išgerti piliulę. Taip pat bakterijas būtų galima paversti tepalu, kuris šildytų ar atliktų kitą funkciją. I.Rauluševičiūtė priduria, kad, naudojant tokias priemones, nereikėtų naudoti cheminių medžiagų.
„Kai geriami vaistai, ne veltui sakoma – nuo vieno padeda, devyniems pakenkia. Juk veikliosios medžiagos tabletėje yra labai mažai, gausu pagalbinių medžiagų. Gydymas bakterijomis būtų daug efektyvesnis. Ateityje galbūt tai prasibraus pro žmonių naujovių baimės barjerą. Bus galima pradėti normaliai naudoti visus GMO. Bakterijos bus visraktis, bet reikia labai daug darbo ir galimybių, norint nukonkuruoti farmacijos įmones“, – sako I.Olendraitė.
Projektas gali būti pritaikomas ne tik žmonėms
„International Genetically Engineered Machine“ konkursui besiruošiančioje komandoje šiuo metu yra aštuoni žmonės. Pasak I.Olendraitės, kiekvienas iš jų aktyviai rengia projektą genetinės inžinerijos, kitaip sakant, IGEM, konkursui, nes visi nori būti įvertinti tarptautiniu mastu Jungtinėse Amerikos Valstijose (JAV) rugsėjo mėnesį.
„Ši idėja kilo labai ilgai ir sunkiai, nes konkurse kiekvienais metais daugėja komandų, labai daug idėjų išnaudota. Žiemą ir pavasarį susitikdavome kiekvieną savaitę ir siūlydavome idėjas. Galiausiai priėjome mintį, kad norime užprogramuoti žmonių naudojamus genetiškai modifikuotus produktus, kad jie, atlikę savo darbą, numirtų.
Pagalvojome – būtų gerai, kad bakterijos turėtų kažką iš vidaus, kas jas po tam tikro laiko numarina. Reikalinga kontrolė. Tai – didelė problema. Bijoma, kad šios bakterijos gali nukonkuruoti natūraliai esančias organizme, nes modifikavimas yra bakterijų patobulinimas“, – aiškina I.Olendraitė.
Ji atskleidžia, kad buvo svarstoma tokiu būdu patobulinti anksčiau minėtame konkurse dalyvavusį projektą. Jis pristatė bakteriją, kuri, patekusi į bitės organizmą, nustato, ar jame yra grybas, sukeliantis pavojingas bičių ligas, dėl kurių dažnai išmiršta spiečiai. Jeigu grybas randamas, bakterija nužudo bitę, kad ši neapkrėstų kitų ir liga neplistų.
„Mes į tokią bakteriją įdėtume savo sistemą, kad ji nenužudytų bitės. Paprastai nužudžiusi grybą ir likusi bitės organizme, bakterija galėtų pakenkti vabzdžiui, jei liktų gyva. Naudojant mūsų sistemą, bakterija nužudytų grybą, pagyventų, pavyzdžiui, dvi savaites, ir pati numirtų. Bitė liktų sveika“, – pateikia pavyzdį I.Olendraitė.
Ši komanda – pirmoji iš Baltijos šalių, kuri pasiryžo dalyvauti tokio masto konkurse. Nors konkursas neapdovanoja laimėtojų piniginėmis premijomis ar ypatingais prizais, komanda nenusimena, nes konkurse dalyvauja vedama visai kitų tikslų. I.Rauluševičiūtė teigia, kad komanda dalyvauja dėl savo ateities, pažinčių, nori garsinti Lietuvos vardą ir plėsti turimas žinias.